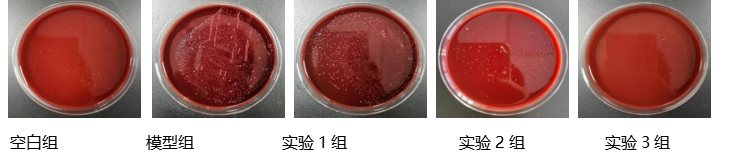
图片4.png

IOBPRO®后生元系列:副干酪乳酪杆菌 IOB413后生元 科普(二)
今天,我们要讨论的是胃部不速之客——一种名为幽门螺杆菌(Helicobacter pylori,简称H. pylori)的细菌,它不仅具有传染性,而且与口臭、胃肠道疾病的发生密切相关[1]。如果您或您身边的人感染了幽门螺杆菌,那么了解相关的知识和改善方法就显得尤为重要。
幽门螺杆菌是一种螺旋形、微厌氧、对生长条件要求十分苛刻的细菌。它能够在人体的胃部存活并繁殖,主要通过口-口和粪-口途径进行传播。

01
高感染率、高致病风险
2023年6月,中国疾控中心传染病预防控制所发布《中国幽门螺杆菌感染防控》白皮书。白皮书指出,幽门螺杆菌是一种与多种重大慢性疾病相关的致病菌,具有传染性。我国幽门螺杆菌人群感染率近50%,不同人群感染率在35.4% -66.4%之间,农村感染率高于城市,成人感染率高于儿童。
幽门螺杆菌常寄生于胃黏膜组织中。感染后,主要引起慢性胃炎和消化性溃疡等疾病,与胃癌等疾病有密切关系[2]。幽门螺杆菌是慢性胃炎的主要致病菌,几乎所有感染者都会存在不同程度的慢性胃炎,幽门螺杆菌还与消化性溃疡的发生密切相关,尤其是十二指肠溃疡。此外,幽门螺杆菌感染还是胃癌的重要致病因素之一。世界卫生组织(WHO)已将幽门螺杆菌列为第一类致癌因子,认为它是胃癌的主要病因之一。大概超过90%的胃癌归因于幽门螺杆菌感染,相当于吸烟引发肺癌的比例[3]。
02
如何判断自己是否感染幽门螺杆菌
通常来说,感染幽门螺杆菌(Helicobacter pylori,Hp;又称幽门螺旋杆菌)初期没有特别明显的表现,但是如果发生以下症状,大家就要小心是否已经感染Hp。

1、上腹部不适、胃部饱胀感、隐痛、反酸、嗳气。
2、口臭:感染幽门螺旋杆菌后,细菌产生的分泌物所带来的臭味会通过口腔散发出来。
3、消瘦、贫血:由于消化不良,人体的营养摄取出现问题,会出现消瘦,甚至贫血的表现。
有以上症状可到医院进行进一步检测,Hp的检测主要包括两类,一类是在做胃镜检查时,医生通过获取一些胃黏膜组织来检测Hp的定植情况;另一类是通过检测血清或C13/C14呼气试验等方法来确认是否感染Hp。
Hp的传播往往呈现家庭聚集传播,因此以家庭为单位的防护是最好的。Hp的家庭传播往往通过饮食发生感染,可以通过以下措施进行防护:
1.保持饮食干净卫生、餐具清洁干净
2.分餐制、使用公筷公勺
3.注意个人卫生、餐前勤洗手
03 已经感染幽门螺旋杆菌该如何干预 《第六次全国幽门螺旋杆菌感染治疗指南2022》推荐铋剂四联14天疗程作为Hp感染者的初次和再次治疗的方案。 如今,临床四联疗法根除Hp正在面临严峻的挑战。研究发现,全球大部分地区幽门螺旋杆菌对抗生素的耐药性显著增加,且临床研究发现四联治疗的根除率在同步下降。另一方面,抗生素疗法产生的胃肠道不良反应也导致感染者对临床治疗的抗拒。 因此,寻找替代性抗幽方案成为功能性食品开发的热点。 IOBPRO®副干酪乳酪杆菌IOB413后生元粉 IOBPRO®副干酪乳酪杆菌IOB413后生元粉是利用自主研发的先进的固态发酵培养技术平台体系,将专用菌株按其特性于特定条件下接入固态发酵物中,再将发酵物经过热灭活处理,获得富含后生元的微生态食品,发酵过程无任何非天然物质添加*。 *:IOBPRO®副干酪乳酪杆菌IOB413后生元粉配料为:大豆、副干酪乳酪杆菌IOB413。 创源生物联合天津科技大学进行了体外筛选实验以及动物验证试验。 科学论证 专利支撑 ※作用机理(基于动物验证实验): 1、IOBPRO®副干酪乳酪杆菌IOB413后生元粉能够降低胃部炎症因子TNF-α、IL-1β表达水平,从而可以缓解胃部炎症。 2、IOBPRO®副干酪乳酪杆菌IOB413后生元粉能够降低胃黏膜幽门螺杆菌的数量,抑制幽门螺杆菌的生长,缓解幽门螺旋杆菌感染。 3、IOBPRO®副干酪乳酪杆菌IOB413后生元粉能够减少胃黏膜白细胞浸润,进一步降低胃部炎症。 综上,IOBPRO®副干酪乳酪杆菌IOB413后生元粉能够抑制小鼠胃部幽门螺旋杆菌生长、缓解胃部炎症和幽门螺杆菌感染。 ※实验结果(动物验证实验;幽门螺旋杆菌感染小鼠模型):
炎症因子
炎症因子

染色切片
胃粘膜幽门螺杆菌定量培养

胃粘膜幽门螺杆菌快速尿素酶检测结果
※ 专利展示:副干酪乳酪杆菌IOB413后生元粉活性成分的制备方法及应用,中国发明专利,专利号:ZL 202311302088.8

参考文献:
[1]董潇阳.幽门螺杆菌口腔与胃内感染的相关性及口腔微生态研究[D].中国人民解放军海军军医大学,2024.DOI:10.26998/d.cnki.gjuyu.2024.000228.
[2]王识宇, 袁德成, 顾芳, 齐泽华. 幽门螺旋杆菌感染对胃癌的影响研究[J]. 中国临床实用医学, 2017, 8(2): 42-47.
[3]逯涛峰.HIF1A调控m6A阅读子YTHDF2促进胃癌进展的机制研究[D].甘肃中医药大学,2023.DOI:10.27026/d.cnki.ggszc.2023.000252.
津公网安备12011602300197